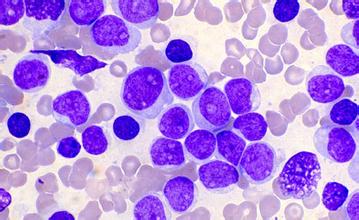

中医特色
当前位置:首页 > 中医特色>-

脑癌2015-07-24
典型表现 脑癌最易出现的就是颅内高压症状,主要表现为头痛,呕吐和视神经乳头水肿。 ... -

乳腺癌2015-07-24
典型表现 本病多发生在40-60岁绝期前后的妇女,男子乳癌少见。乳癌中医学称为乳岩,以其乳房肿块坚硬如石而得名。又有医书称之为石榴翻花生,以其晚期破溃烂后状如石榴翻花而得名,其命名异,但病实为一个。 ... -
白血病2015-07-24
典型表现 白血病是血液及造血器官的恶性疾病。主要表现有发热、贫血、出血、肝脾及淋巴肿大,骨髓和周围血象中的白细胞有质和量的异常变化。 ... -

宫颈癌2015-07-24
典型表现 早期症状,多数系在妇科普查时才发现。晚期见白带曾多、状如米汤、或血性白带、奇臭、不规则阴道出血、贫血、下腹部剧痛、消瘦、发热、纳差、或尿频 ...







